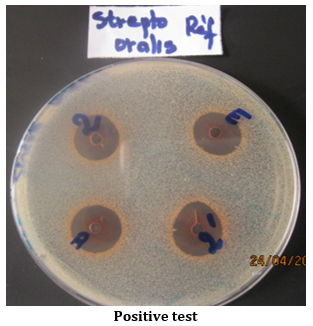
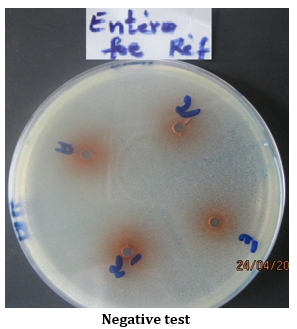

1Laboratoire de Biologie et de Typage Moléculaire en Microbiologie, FAST, Université d’Abomey Calavi 05 BP: 1604 Cotonou, Bénin, 2Laboratoire des Ressources Génétiques et d’Amélioration des Espèces, Département de Génétique et des Biotechnologies, FAST, Université d’Abomey Calavi, BP: 526 Cotonou, Bénin, 3Université Péléforo Gon Coulibaly de Korhogo UFR des Sciences Biologiques BP: 1328 Côte d’Ivoire, 4Laboratoire de Microbiologie et de Technologie Alimentaire, FAST, Université d’Abomey-Calavi, 01 BP: 526 ISBA-Champ de foire, Cotonou Bénin, 5Centre de Recherches Agricoles Sud, Institut National des Recherches Agricoles du Bénin, Attogon BP: 884 Cotonou, Bénin, 6Laboratoire de Pharmacognosie et des huiles essentielles, FSS/UAC 01 BP: 4521 Cotonou, Benin
Email: laminesaid@yahoo.fr
Received: 09 Mar 2015 Revised and Accepted: 04 Apr 2015
ABSTRACT
Objective: The aim of this study was to make a phytochemical screening and measure some biological activities of Cola acuminata’s seeds and leaves extracts.
Methods: The secondary metabolite was detected by the method based on coloring and precipitation differential reactions. The antibacterial and antifungal activities were assessed in vitro by the macrodillution and solid medium agar diffusion method. 2,2-diphényl-1-picrylhydrazyl (DPPH) and 2,2’-azinobis-(3-ethylbenzothiazoline-6-sulfonic acid) (ABTS) methods were used to evaluate the antioxidant activity of the tested extracts of which larval cytotoxicity was studied.
Results: Our data revealed that the seeds contain more polyphenols than the leaves. The seeds extracts displayed a good antibacterial activity against both reference strains and food Staphylococcus strains. The inhibition diameters varied from 7±2.82 to 21.5±4.94 mm. The smallest Minimum Inhibitory Concentrations (MIC) on the food strains (0.08 mg/ml) is twice less than the reference strains one (0.15 mg/ml), this observation is contrary to the Minimum Bactericidal concentrations (MBC). Susceptibility of fungal strains varies according to the extracts (p = 0.0016). The seeds ethyl acetate extracts had the best antioxidant activity with DPPH and ABTS methods. The Lethal Doses (LD50) showed that no extract was toxic.
Conclusion: Cola acuminata seeds are richer than the leaves in compounds with biological activities. These two organs have interesting antimicrobial, antifungal and antioxidant activity variables depending to the extracts. The seeds have better biological activity than the leaves.
Keywords: Metabolites, Extracts, Staphylococcus, Antimicrobial, Meat products, Benin.
INTRODUCTION
The major part of an African population lives in rural areas and depends primarily of natural resources for their health care [1], subsistence and income acquisition. Bacteria and fungus are involved to cause over 250 types of clinical and food poisoning infections. Indeed, the pathogens frequently incriminated in clinical infection and food poisoning belongs to the genus Staphylococcus, Pseudomonas and Escherichia [2-4]. These bacteria are also responsible of most no-food infections like venereal disease, deep wound [5] and the food deterioration that can be caused by bacterial toxins. Apart the bacterial toxins, mycotoxins are fungal secondary metabolites likely to contaminate the animal and human feeds at all stages of the food chain [6]. The toxigenic molds are mainly Aspergillus spp, Penicillium spp and Fusarium spp [7]. In the treatment of these diseases, because of the misuse and often uncontrolled synthetic products used, the control of bacterial and fungal infections becomes complex due to the emergence of resistant bacteria and fungi to many conventional antibiotics and antifungal.
Moreover, in several serious pathologies, the involvement of free radicals is also proven. Indeed the body has its own means defenses allowing him to fight against free radicals. When this protection system loses its effectiveness, there occurs an oxidative stress [8], which can trigger a series of molecular and cellular event inducing multiple consequences such as cancers [9] cerebro-and cardiovascular diseases, diabetes and high blood pressure [10].
In Benin, many cases of multi antibiotic-resistant bacteria are reported by Sina et al. [11]. To face the multidrug resistance, many studies in the country have proven the effectiveness of medicinal plants in the fight against certain fungal strains [12], and pathogenic Gram positive and Gram negative bacterial involve in several pathologies [13].
Faced the bacterial and fungal strains resistance to almost all antibiotics and antifungals used nowadays [14], and the incapacity of endogenous antioxidant systems to protect without failure biological macromolecules opposite the oxidative stress, research of extracts becomes necessary. The most reliable and easy way is the capitalization of endogenous knowledge through the medicinal plants study. In this context, it should be noted that considerable efforts were necessary to undertake ethnobotanical studies to identify local uses of several plant species [15, 16].
C. acuminata, belongs to the Sterculiaceae family [17] originated from West Africa. It is a very special and important plant used in social and ceremonial activities by Africans. Presently, the dried nuts of C. acuminata have been found useful in the production of some beverages and for pharmaceutical purposes. Investigations conducted in Benin have proved that the plant has huge ethnobotanical values. Several parts of the plant are used traditionally in the treatment of certain disease. C. acuminata is reputed elsewhere for its many medicinal properties [18, 19]. In Benin, this species has been very little study, particularly at its medicinal level. The reference related to its phytochemical composition and biological properties are quasi non-existent. Thus, our study aims not only to identify the phytochemicals constituents of Benin’s C. acuminata, but also to investigate the biological activities (antibacterial, antifungal, antioxidant and cytotoxic) of its extracts.
MATERIALS AND METHODS
Collection of plant material
The seed and leaves of C. acuminata used in this study were collected in the village of Atchoukpa (commune of Avrankou: 6 °29’09”N, 2 °40’13”E) department of Oueme, southern Benin. Once collected, the plants materials were air dried at 25 °C–30 °C for two weeks before grinded into powder. The smooth powder was stored in airtight glassware and kept in darkness at -20 °C until use.
Phytochemical profiling
The phytochemical profiling of C. acuminata’s seed and leaves were done according to Houghton and Rahman [20]. This profiling focused on the determination of some constituents such as nitrogenous, polyphenolic, terpenic compound, and glycosides.
Preparation of aqueous and dichloromethane extracts
The aqueous and dichloromethane extracts of the collected vegetal material was obtained by using an adaptation of the method developed by Guede-Guina et al. [21]. Briefly, the powder (50 g) of C. acuminata’s appropriate organ (leaf or seed) obtained above was macerated in 500 ml of each solvent (distilled water and dichloromethane) under magnetic agitation for 72 h at room temperature. The homogenate was then filtered two times on absorbent cotton and once on Whatman N °1 paper (125 mm ø, Cat No 1001 125). For the aqueous extract, the filtrate was directly dried in the oven at 40 °C. The filtrate of dichloromethane was concentrated in vacuum using a rotary evaporator (Heidolph Instruments GmbH & Co. KG No: 591-28000-00-1) to obtain the extract. The extracts were stored in labeled sterile bottles and kept at-20 °C until further use.
Preparation of ethanol and Ethyl acetate extracts
These extracts were made using an adapted method of the one described by Sanogo et al. [22] and N’Guessan et al. [23]. This method consisted of macerating 50 g of C. acuminata powders (leaf or seed) in 500 ml of 96% ethanol for 72 hours. The obtained extract was filtered thrice using Whatman N °1 filter paper (125 mm ø, Cat No 1001 125). Half of the filtrate was directly dried at 40 °C to obtain the ethanolic extract of C. acuminata. To the second half of the filtrate, 200 ml of H2O and 100 ml of ethyl acetate were added. The solution was gently mixed and left settled until we obtain two phases (about 45 min). The lower phase was collected and dried as described previously to obtain the ethyl acetate extract. The alcoholic and ethyl acetate extracts was stored in labeled sterile bottles and kept at -20 °C until further use.
Microorganism’s cultures
The tested microorganisms include ten references, twenty height Staphylococcus meat isolated strains and three fungal strains (Penicillium citrinum, Aspergillus tamarii and Fusarium verticilloides). The three fugal strains were part of the microorganisms isolated in a Beninese traditional cheese wagashi by Sessou et al. [11]. The reference strains were Escherichia coli ATCC 25922, Staphylococcus aureus ATCC 29213, Staphylococcus epidermidis T22695, Pseudomonas aeruginosa ATCC 27853, Proteus mirabilus A24974, Micrococcus luteus ATCC 10240, Proteus vulgaris A25015, Streptococcus oralis, Enterococcus faecalis ATCC 29212, Candida albicans MHMR. The Staphylococcus strains use in this study were those isolated from three different meat products in Ivory Coast by Attien et al. [24] and stored in the Laboratory of Biology and Molecular Typing in Microbiology (University of Abomey-Calavi, Benin).
Antimicrobial activity
Sensitivity test
The agar perforation method inspired from those of Bauer et al. [25] was used to screen the antimicrobial activity. Briefly, four to five perforations were performed under aseptic conditions, on Mueller Hinton agar petri dish previously flooded of the appropriate bacterial culture (adjusted to 0.5 McFarland standard). Twenty five microliter of C. acuminata’s extract solution (20 mg/ml) was aseptically lodged in the hole. These dishes were kept for 15-30 min at room temperature before incubation at 37 °C for 24 and 48 h.
After the incubation period, the dishes were examined for inhibitory zones. Each sample was used in triplicate for the determination of antibacterial and antifungal activity.
Determination of minimum inhibitory concentrations (MIC)
The MIC of plants extract was performed by macrodilution method [26]. First, the extracts were diluted in sterilized distilled water to the highest concentration of 20 000 μg/ml and then nine dilution were performed to obtain the concentrations of 10 000 μg/ml, 5 000 μg/ml, 2 500 μg/ml, 1 250 μg/ml, 625 μg/ml, 312.5 μg/ml, 156.25 μg/ml, 78.12 μg/ml and 39.06 μg/ml in screw tube. To 1 ml of the above concentrations was added 1 ml of the bacteria inoculum (106 UFC/ml) to obtain 2 ml as a final volume. Culture medium without samples and others without microorganisms was used in the tests as control. Tubes were incubated at 37 °C for 18-24 h and growth was indicated by turbidity. The MIC is the lowest concentration of the compound at which the microorganism tested does not demonstrate visible growth (turbidity).
Minimum bactericidal concentration (MBC)
The MBC of the tested microorganisms was determined by sub culturing the test dilutions onto a fresh solid medium and incubated further for 18-24 h. The highest dilution that yielded no bacterial growth on solid medium was taken as MBC [27].
Evaluation of the cytotoxicity activity of Cola acuminata extracts
The cytotoxic effect of the extracts was evaluated according to an adaptation of the method described by Kawsar et al. [28]. The tests are carried out twice on 72 h larvae of Artemia salina. Briley, a test was constituted of 16 A. salina larvae in a 2 ml solution containing 1 ml of the extract tested concentration and 1 ml of sea water. The number of surviving larvae is counted after incubation (24 h) and the DL50 was calculated using the regression line obtained from the surviving larvae in function of the extracts concentration representation.
Antifungal activity
The in vitro antifungal activity of the extracts was evaluated according to the method previously described by Dohou et al. [29]. The assay was performed on the Potato-Dextrose Agar medium. Briefly, the extracts (20 mg/ml) use for the antifungal activity was dissolved with sterilize distillated water (1 ml) or if necessary with a water-ethanol mixture (60:40). One ml of the dissolved extract (20 mg/ml) was thoroughly mixed with 10 ml of the sterilized Potato-Dextrose Agar medium before it transferred to sterile petri dishes for solidification. After the medium solidification, a sterile disc (6 mm) first treated with fungal strain was placed in each Petri plate. Each treatment was replicated twice. Plates were incubated at 25±1 °C for 5 days. Fungal radial growth was measured by averaging the two diameters taken from each colony. Percentage growth inhibition of the fungal colonies was calculated using the formula below:

Antioxidant activity determinations
The antioxidant activity was measured using both DPPH and ABTS methods.
The ABTS assay was conducted according to the method described by Re et al. [30]. The working solution of ABTS+(10 mg of ABTS, 2.6 ml of deionized water and 1.72 mg of potassium persulphate) was left to stand at room temperature for 12 h in the dark before use. This solution was diluted with ethanol until obtaining an absorbance of 0.70±0.02 at 734 nm. Twenty µl of each extract sample (1 mg/ml) was diluted with a fresh prepared ABTS solution to a total volume of 1 ml. All the assays were performed in triplicates, the absorbance was read after 15 min in dark at 734 nm and the reference molecule was ascorbic acid. The concentration of compounds with a capability to reduce ABTS+radical cation is expressed as µmol equivalent Ascorbic Acid (µmol EqAA) per gram of dry extract using the formula used by Guenne et al. [31].
The DPPH method was conducted following an adaptation of the method described by Scherer and Godoy [32]. Equal volumes (100 µl) of DPPH (50 μM) and plant extracts (200 μg/ml) were mixed in a 96 well microplate and allowed to stand in darkness for 20-30 min at room temperature. Then, the absorbance was read at 517 nm and the blank was a mixture of methanol and DPPH (v: v). The inhibitory percentage of DPPH radical indicating the antioxidant activity of extracts and quercetol, gallic acid was obtained using the formula establish by Schmeda-Hirschmann et al. [33]. The concentration providing 50% inhibition (IC50) was determined graphically using a calibration curve in the linear range by plotting the extract concentration and the corresponding scavenging effect. Antioxidant Activity Index (AAI) was calculated according to the formula used by Scherer and Godoy [32].
Statistical analysis
All experiment was done in triplicate and data thus obtained reported as a mean±standard deviation (SD). The data were analyzed using Graph Pad Prism 5 software. Differences of p<0.05 were considered significant.
RESULTS
Phytochemical profile
The results of the qualitative phytochemical screening of C. acuminata organs collected from Benin shown that the seeds contained 45% of the studied secondary metabolites while the leaves contained 20%. Indeed, in the seeds we observed the presence of tannins, flavonoids, Leuco-anthocyanes, Triterpenoids, Steroids, Saponosids and Reducing compounds, also we noted the absence of Alkaloids and Cyanogenics derivative. In the leaves, we noted the presence of alkaloids, tannins and cardenolids.
Antimicrobial activity of Cola acuminata extracts
The results of sensitivity tests of microorganisms against C. acuminata extracts showed that the leaves’ ethanol extract inhibited the growth of several microorganisms at different (variable) level (fig. 1). The leaves’ aqueous, dichloromethane and ethyl acetate extracts had not inhibited the growth of any tested microorganism. Likewise, for the seeds, a part of the dichloromethane extract, the ethanol, aqueous and ethyl acetate extracts inhibited the growth of the microorganisms.

2’: Seeds ethyl acetate extract, 2: Leaves ethanol extract, E: Seeds aqueous extract, A: Seeds ethanol extract
Fig. 1: Possible results displays after sensitivity test of strains to Cola acuminata extracts
Sensitivity of reference strains to Cola acuminata extracts
With C. acuminata’s leaves, our data shows that the ethanol extract inhibited about 80% of the reference strains tested (fig. 2a). The inhibition diameters had highly varied according to the strains (p < 0.0001). The inhibition diameters, does not globally vary (p > 0.05) considering the data recorded in the time (24 h and 48 h). Only P. vulgaris strain had displayed a variation of diameters in the time (p < 0.05). With the leaves extract, the highest inhibitory diameter (12.5±0.98 mm) was obtained with P. vulgaris after 48 h of incubation.
Considering C. acuminata’s seeds, the broad spectrum of activity were observed with the ethyl acetate extract that inhibit 60% of the tested reference strains (fig. 2c). The inhibitory diameters after incubation times (24 h and 48 h) was significantly varied (p < 0.001) for three strains (S. aureus, S. epidermidis, M. luteus and P. vulgaris). As for ethanol and aqueous extracts, their inhibition diameters had significantly varied according to the tested reference strain. To compare the inhibition diameter recorded (on the same strains) both after 24 h and 48 h of incubation, a significant increase was observed with C. acuminata’s seeds aqueous extract on S. aureus (p < 0.01). The largest inhibition diameter obtained with the ethyl acetate extract, (25±0.56 mm) after 48 h of incubation was recorded with S. aureus. The largest diameter with C. acuminata’s ethanol extract was 15±00 mm while the one recorded with the aqueous extract was 13±0.28 mm (fig. 2d) on S. aureus. We noted that the most sensitive strains to all C. acuminata’s seeds active extracts was S. aureus. The less sensitive strains to the ethanol extracts and ethyl acetate was M. luteus, whereas S. epidermidis was less sensitive to the aqueous extract.
In addition, the sensitivity of microbial strains had not varied only according to the extract kind but also to the organs used for the extractions. The effect of a same extract kind of the two organs showed that leaves ethanol extract did not inhibited as much as seeds ethanol extract. The largest diameter (15±00 mm) of the ethanol extracts was observed with seed extract. For the same organ, the inhibitory action of a given extract strongly varied according to the tested microorganism (p < 0.0001).
Sensitivity of meat isolated Staphylococcus strains to Cola acuminata extracts
The inhibition zones diameters of food isolated strains varied from a species to another according to the kind of extract and the plants organs (leaves and seeds). The seeds ethanol extracts has a broad spectrum of action on the food isolated strains. It was observed a variation of inhibition diameters according to the incubation time (24 h and 48 h) (fig. 2f). The seeds ethanol extracts was more effective than the aqueous one which inhibits half of food isolated strains (fig. 2h). The tested strains displayed less sensitivity to leaves ethanol extracts (fig. 2e) and seeds ethyl acetate extract (fig. 2g). The compared action of the same organ extracts showed that the seeds ethanol extracts had the best inhibition diameter (20.25±0.55 mm). Nevertheless, S. lentus had not presented a resistance to all extracts of seeds.
Minimum Inhibitory and Bactericidal Concentrations (MIC and MBC) of Cola acuminata extracts on reference strains
The reference strains’ MIC varied from 0.15 mg/ml to 5 mg/ml whereas the MBC varied from 0.625 mg/ml to C>20 mg/ml (table 1). The ratio MBC/MIC showed that the leaves ethanol extract had more bactericidal activity than the seeds ethanol extract which presented only bacteriostatic effects. Besides, the seeds ethyl acetate extract presented a bactericidal effect on S. aureus, S. epidermidis and M. luteus whereas the bactericidal effect of it aqueous extracts was obtained only with S. oralis (table 1).
Minimum Inhibitory and Bactericidal Concentrations (MIC and MBC) of Cola acuminata extracts on meat isolated Staphylococcus strains
The MIC of the food isolated strains varied from 0.08 mg/ml with seeds ethanol extract (S. equorum) to 5 mg/ml with the seeds ethyl acetate (S. lentus) and aqueous extracts (S. xylosus and S. equorum) (table 2). The smallest MBC (2.5 mg/ml) was obtained with the seeds ethanol extract. The ratio MBC/MIC indicates that only the seeds ethyl acetate extract had a bactericidal effect observed with S. lentus. The tested seeds extracts displayed less bactericidal effect on the food isolated Staphylococcus strains.
Antifungal activity of Cola acuminata extracts
Fig. 3 indicated that the antifungal activity using 1.8 µg/ml of different tested C. acuminata’s extracts was significantly variable according to the used fungal strains (p < 0.0001). The inhibitory rate of the mycelia development (growth) varied from 0% to 57.8%. The greatest percentage of inhibition was obtained with the seeds ethyl acetate extract against F. verticillioide. Among the three tested funguses strains, F. verticillioide and A. tamarii were more sensitive to ethyl acetate extract of seeds, while P. citrinium was more sensitive to ethanol extract of leaves. The interaction between the strains and some extracts (seeds ethanol and aqueous extracts) displayed a difference of action. For aqueous extract, the inhibition rate of F. verticillioide was higher than the one recorded with P. citrinium (p < 0.01). For ethyl acetate extract, the inhibition rate’s difference was significant between F. verticillioide and P. citrinium (p<0.001). With the leaves ethanol extracts, there was not any difference independently to the strains (p>0.05).

Fig. 2: Medium inhibitory diameter zone of C. acuminata extracts on reference and meat isolated Staphylococcus strains after 24 h and 48 h of incubation
For reference strains: S. aur: Staphylococcus aureus, M. lut: Miccrococcus luteus, S. epi: Staphylococcus epidermidis, S. ora: Streptococcus oralis, Ps. aer: Pseudomanas aeruginosa, E. foe: Enterococcus foecalis, P. vul: Proteus vulgaris, E. coli: Escherichia coli, C. alb: Candida albicans, P. mir: Proteus mirabilis; For meat isolated strains: S. sci: S. sciuri, S. aur: S. aureus, S. sim: S. simulans, S. xyl: S. xylosus, S. coh: S. cohnii, S. equ: S. equorum, S. sap: S. saprophyticus, S. hae: S. haemolyticus and S. len: S. lentus. *: p<0.05; **: p<0.01; ***: p<0.001.
Table 1: Minimum Inhibitory (MIC) and Bactericidal (MBC) Concentrations of C. acuminata extracts on references strains
| Extracts | Parameters (mg/ml) | References strains | |
| S. aur | S. epi | ||
| Leaves ethanol extract | MIC | 0.31 | 0.62 |
| MBC | 0.62 | 10 | |
| MBC/MIC | 2٭ | 16 | |
| Seeds ethanol extract | MIC | 0.31 | - |
| MBC | 5 | - | |
| MBC/MIC | 16.02 | ||
| Seeds ethyl acetate extract | MIC | 1.25 | 0.62 |
| MBC | 2.5 | 0.62 | |
| MBC/MIC | 2٭ | 1٭ | |
| Seeds aqueous extract | MIC | 0.31 | 5 |
| MBC | 5 | >20 | |
| MBC/MIC | 16.02 |
MIC= Minimum Inhibitory Concentration, BMC= Minimum Bactericidal Concentration, With *= Bactericidal effects and without * = Bacteriostatical effects, S. aur: Staphylococcus aureus, M. lut: Miccrococcus luteus, S. epi: Staphylococcus epidermidis, S. ora: Streptococcus oralis, Ps. aer: Pseudomanas aeruginosa, E. foe: Enterococcus foecalis, P. vul: Proteus vulgaris, E. coli: Escherichia coli, C. alb: Candida albicans, P. mir: Proteus mirabilis
Table 2: Minimum Inhibitory Concentrations (MIC) and Bactericidal (MBC) of C. acuminata extracts on meat isolated Staphylococcus
| Extracts | Parameters (mg/ml) | Meat isolated Staphylococcus |
| S. xyl | ||
| Leaves ethanol extract | MIC | 1.25 |
| MBC | 10 | |
| MBC/MIC | 8 | |
| Seeds ethanol extract | MIC | 1.25 |
| MBC | 5 | |
| MBC/MIC | 4 | |
| Seeds ethyl acetate extract | MIC | - |
| MBC | - | |
| MBC/MIC | ||
| Seeds aqueous extract | MIC | 5 |
| MBC | >20 | |
| MBC/MIC | - |
MIC= Minimum Inhibitory Concentration, BMC= Minimum Bactericidal Concentration, With *= Bactericidal effects and without * = Bacteriostatical effects, S. xyl: S. xylosus, S. len: S. lentus, S. sim: S. simulans, S. sci: S. sciuri, S. coh: S. cohnii, S. equ: S. equorum, S. sap: S. saprophyticus, S. hae: S. haemolyticus and S. aur: S. aureus
Antioxidant activity of Cola acuminata extracts
Radical DPPH scavenging activities of the tested extracts are shown in table 3. The extracts reducing power shown that the ethyl acetate extract of the seeds has the smallest IC50 (4.36±0.66 μg/μl). This extract was followed by the seeds ethanol extract with an IC50 of 11.00±0.42 μg/μl. The aqueous extract of seeds presented an intermediate activity while leaves ethanol extract had the lowest DPPH radical scavenging. The reducing power of the seeds ethyl acetate extract was higher than the reference molecule (BHT) one. On the other hand, gallic acid and ascorbic acid respectively have an activity four times, and twice higher than the one of the seeds ethyl acetate extract. In addition to the IC50, the table 3 presents the Antioxidant Activity Index (AAI). The observation of these results shows that ethyl acetate and ethanol extracts of seeds have good reducing power of DPPH radical.
Considering the ABTS radical cation decoloration capacity, the extracts activity decreases as follows: leaves ethanol < seeds aqueous < seeds ethanol < seeds ethyl acetate (table 3). Seeds ethanol extract has an activity very close to the one observed with ethyl acetate extract.
Contrary to the DPPH method, the reducing power of the seed extracts (ethyl acetate and ethanol) was greater than the one of ascorbic acid (35.02±0.73 µmol EqAA/g) used as the standard. Through the two methods, seeds extracts of C. acuminata have shown good antioxidant activity.

Fig. 3: Inhibition rate of Cola acuminata extracts in the fungal growth
SEE: Seed’s Ethanol Extract, LEE: Leaves’ Ethanol Extract, SAE: Seed’s Aqueous Extract, SEAE: Seed’s Ethyl Acetate Extract.
Table 3: Antioxidant activities of Cola acuminata extracts and reference molecule
| DPPH | ABTS | |
| IC50 (µg/µl) | IAA | |
| Seeds ethanol extract | 11.00±0.42 | 4.54±0.17 |
| Seeds ethyl acetate extract | 4.36±0.66 | 11.62±1.69 |
| Seeds aqueous extract | 32.18±0.27 | 1.55±0.48 |
| Leaves ethanol extract | 158.00±14.14 | 0.31±0.02 |
| BHT | 6.70±0.12 | 7.46±1.52 |
| Gallic Acid | 0.8±0.07 | 62.74±5.54 |
| Ascorbic Acid | 2.8±0.40 | 18.10±2.53 |
nd: not determined
Cytotoxic activity of Cola acuminata extracts
The data relating to the variation of larvae mortality according to used concentrations of C. acuminata extracts shows that the larvae mortality started with leaves ethanol extract (0.26 mg/ml) followed by the seeds ethanol and ethyl acetate extracts (2.08 mg/ml) and then the seeds aqueous extract (4.16 mg/ml). The larval mortality follows a dose-response gradient effect. Lethal doses inducing 50% mortality (LD50) of the larvae population varied depending to the extract. Indeed, according to the kind of extract, we obtain successively LD50 of 3.56 mg/ml (leaves ethanol extract), 6.59 mg/ml(seeds ethyl acetate extract), 10.05 mg/ml(seeds ethanol extract) and 11.01 mg/ml(aqueous extract of seeds).
DISCUSSION
This study shows the presence of phytochemical elements in seeds and leaves of C. acuminata with varying biological activities of their extracts. Our funded data concerning the tannins and flavonoids corroborate those of several authors in Nigeria [34-36]. The absence of the alkaloids in the seeds was already reported by Wahab et al. [37]. Meanwhile, we should notice that some studies performed in Nigeria reported the presence of alkaloids in the seeds of C. acuminata [36, 38].
The difference related to the presence of alkaloids observed between our result and the previously cited authors’ could be due to either the origin of the plants or the environmental growth conditions. Indeed, the environmental condition is known to influence the presence and expression of secondary metabolites on a plant [39]. Our data shows the presence of alkaloids in the leaves as reported by Sonibare et al. [40]. This observation on leaves shows that this compound is present in the plant and its expression vary from an organ to another. In the two organs no cyanogenic derivatives were founded. These compounds are the causes of toxicity due to the production of cyanide ions after their ingestion and expressed by the acceleration and amplification of respiratory rate, respiratory depression, dizziness, headache, disturbance of consciousness, coma etc [41].
The antimicrobial activity on the reference strains shows that among the leaves extracts, only the ethanol extract was active, whereas the aqueous, ethanol and ethyl acetate extracts of the seeds are active at various proportions. The difference observed for the two organs can be linked to the small number of secondary metabolite in leaves compared to seed of the plant. Moreover the affinity of the phytomolecules to the solvents based on to their polarities [42], could be explain the results obtained with ethanol compared to other solvents. Thus, ethanol may concentrate better antimicrobial molecules contained in the leaves of C. acuminata. Indeed, Sonibare et al. [40] demonstrated that the ethanol extract of leaves inhibits the growth of microorganisms such as S. aureus, P. aeruginosa and C. albicans at a concentration of 10 mg/ml.
These results support the hypothesis that ethanol extracts better concentrated antimicrobial agents in the leaves of the plant. Concerning the seeds, Adam et al. [43] also showed the activity of the aqueous extract on S. aureus, E. coli and C. albicans which is in accordance with the observations in this study. The greatest diameter of inhibition obtained with the ethanol extract (20 mg/ml) is 15 mm with S. aureus. The same diameter was observed by Mboto and Udoh [34] in Cameroon on the S. aureus strain but at 50 mg/ml. The results obtained with the ethanol extract of the seeds in this study, are better than those reported by Mboto and Udoh [34]. Thus, it seems appear that antimicrobial active compound are higher in the C. acuminata’s seeds harvested Benin than in those collected in Cameroon. The ethanol extract of seeds has no effect on certain reference strains such as P. aeruginosa, E. foecalis, E. coli, and C. albicans. Beside some authors showed the activity of another type of alcoholic (methanol) extract of seeds on certain reference strains such as P. aeruginosa ATCC 27853, E. foecalis ATCC 29212 and E. coli ATCC 25922 [44-45]. Similarly Lowe et al. [18] reports that the methanol extracts of C. acuminata seed has antimicrobial activity against the strains such as E. coli, C. albicans, B. subtilis, S. aureus, P. aeruginosa and K. pneumonae. The comparison shows that though ethanol and methanol are polar protic solvents, the type of alcohol plays an important role in the solubilization of the active ingredients contained in a plant organ. Regarding the food strains contrary to the reference strains, the ethanol extract of the seeds present the strongest inhibition rate and the largest diameter of inhibition.
The smallest MIC obtained with the food strains (0.08 mg/ml) is twice lower than that of the reference strains (0.15 mg/ml). This observation lets predict that the extracts have an inhibiting effect with low dose on the food strains than on the reference strains. On the other hand, the smallest MBC obtained with the food strains (2.5 mg/ml) is four times higher than that of the reference strains, whereas the ratio of these two parameters according to Berche et al. [46] shows that certain extracts have bactericidal activity while others have a bacteriostatic activity, but there is less bactericidal effect with the food strains.
The extracts of leaves and seeds present antifungal activity depending on the strains. A. tamarii is the strain which presents more antagonism (resistance) to the ethanol extracts of leaves. The ethyl acetate extract of seeds has a better antifungal activity compared to ethanol and aqueous extracts of the same organ. The large number of polyphenolic compounds extracted by ethyl acetate as well as heterosides would be a reliable argument for these observations [47, 48]. The aqueous extract of seeds at 1.8 mg/ml has no effect on A. tamarii, similarly Kanoma et al. [38] also showed that the aqueous extract of seeds at 60 mg/ml, has no effect on A. niger. This found can be explained by the fact that water does not extract a large quantity of polyphenols [49].
The antioxidant activity index (AAI) calculated according to Scherer and Godoy [32], showed that only the leaves ethanol extract has a low antioxidant activity, while the ethyl acetate and ethanol extracts of seeds have a very high antioxidant activity. Using the DPPH method, ascorbic acid which is a pure compound with an IC50 of 2.8±0.40 μg/μl, has an antioxidant capacity higher than the one displays by our extracts. On the other hand, by the ABTS method, our extracts reducing power of ABTS cation is higher than that of ascorbic acid. This difference can be partly explained by the fact that the active molecules may be different from a method to another. Moreover, in view of the incubation time (15 min) of our extracts with DPPH method, these extract could not finish developing their activities. Some molecules in the group of phenolic compounds as the anthocyanes do not show their real power antioxidant after 12 h reaction time. Polyphenols are mainly responsible of reducing power the DPPH radical because of good correlations between the total phenolic content and anti DPPH activity were demonstrated by Fadlinizal et al. [50] with r2 = 0.94 and Topan [51] with r2 = 0.99.
CONCLUSION
The data of our study show that Cola acuminata contains phytochemicals elements (secondary metabolites) much more concentrated in the seeds than the leaves. Moreover, of the four biological activities evaluated, the two organs have interesting antimicrobial, antifungal and antioxidant activity variables depending to the extracts. The seeds of the species have better biological activity than the leaves. In addition, any toxicity was not recorded for the two organs of the plant. These results justify some traditional uses of the plant.
CONFLICT OF INTERESTS
The authors declare that there is no conflict of interests regarding the publication of this document.
ACKNOWLEDGMENT
The authors thank UEMOA for the financial support through the project LBTMM-PAES-UEMOA-2012.
CONFLICT OF INTERESTS
Declared None
REFERENCES